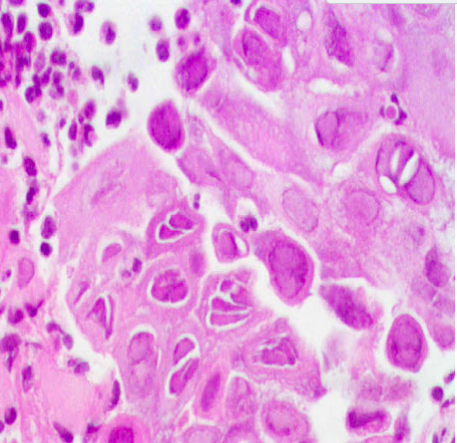

What causes Trichomoniasis?
T. vaginalis, a sexually transmitted protozoan parasite that is a frequent cause of vaginitis.
How does Trich present?
This is typically aymptomatic in men, and may be in women too or may present with pruritis and a profuse, frothy, yellow vaginal discharge. Urethral colonization may cause urinary frequency or dysuria.

Notice the granular appearance

These are picked up commonly in Pap smears inside squamous cells!

What is this?
Genital Herpes simplex marked by margination of chromatin, molding, multi-nucleations, and glassy-like inclusions in the epithelial cells